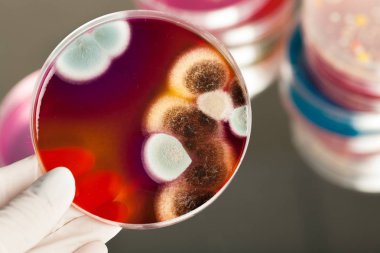
Mikrobiyoloji.
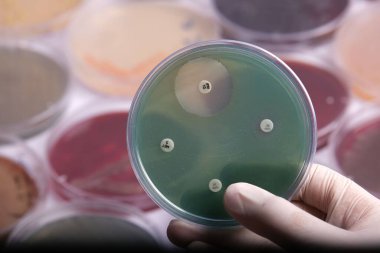
Bakteri kültürü olan bir petri kabını tutan bir el. Arka planda bulanık petri kapları bulunan antibiyotik duyarlılık testini gösteren birkaç küçük disk.
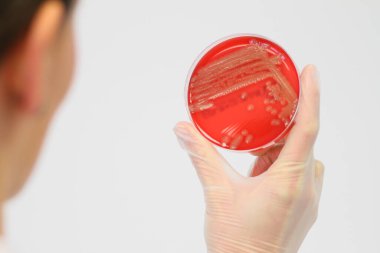
Bakterienkolonien auf einer Agarplatte in einer Hand

Eldiven takan bir el, arka planda çeşitli petri kaplarıyla çevrili kırmızı agar ve mantar kültürü içeren bir petri kabını tutar.
İhlal Bildirim Formu
Özel Boyut
(6240 x 4160, jpg)
Geniş Lisanslama
(6240 x 4160, jpg)
* Kurumsal aylık abonelikte çok avantajlı fiyatlar için tıklayın.
* Fiyatlara Kdv dahil değildir.
Örnek Kullanımlar: Web siteleri; reklam afişleri; ekran koruyucuları; sunumlar (PowerPoint, Flash, vs); filmler, videolar veya televizyon reklamları, gazete ve dergilerdeki reklamlar, bastırılmış reklam materyalleri; kitaplar için kapak, iş kartları; el ilanları; posterler; CD/DVD kapakları, etiketler veya ürün paketleri, kırtasiye, dosya, defterler, tükenmez kalem, kalemler, yapıştırmalar; takvimler; fincanlar veya bardaklar; fare altlığı; tişörtler, kıyafet vs. Detaylı Tablo için Tıklayınız!
En Çok Aranan Kelimeler
Sağlık hizmetleriTıbbiEl.biyolojiDeneyLaboratuvarBilimaraştırmaeldivenBiyoteknoloji.Mikrobiyolojiimmanuel kantLaboratuvar çalışmasılaboratuvar ekipmanıLaboratuvar teknikleriPetri Çanağısteril ortamLaboratuar teknisyeniKültür ortamıKlinik Araştırmabilimsel araştırmanınbilimsel çalışmascientific explorationakademik araştırmaLaboratuar örneklerilaboratory settingeducational purposeexperimental biologylaboratory safetyfungal culturefungi identificationmicrobiological analysisred agarmicrobiome analysisLaboratuvar prosedürleripathogen studyÖrnek analiziMikrobiyolojik testpetri dish collectionBenzer İçerikler